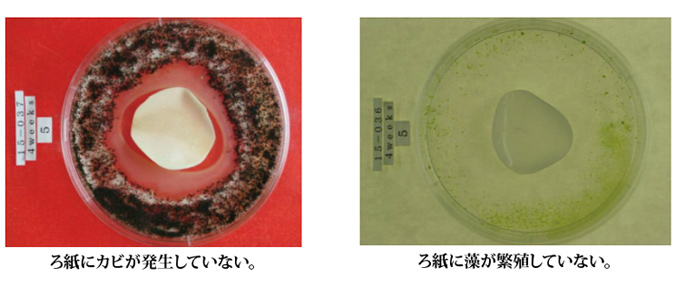
�h�J�r�h�����ʐ^

外壁磁器タイルは恒久性に優れており美観的にも美しいため、建物の外壁に多数採用されています。一般的なタイルのイメージはノーメンテナンスと思われがちですが、経年劣化が起きてしまいます。それにより浮きやクラック、目地の劣化などから外壁から浸水し室内へ漏水してしまうことが多発しています。
一度漏れ出すとどこから浸水しているのかを特定することが非常に困難です。また見つけたとしてもその一箇所だけとは限りません。補修しては様子を見るということを延々くり返しかねません。
転ばぬ先の杖と言う諺どおり、漏れる前に止める処置を行っておく。ということが最も望まれますが、新築時には十年先に改修工事をおこなうのだからなどと、事前処理をする事はまずありません。
しかし環境によっては10年を待たずに劣化が起こってしまい、目地やタイルに微細にクラックが起こり、漏水していることがあります。
漏水するまではいかなくても、目地のモルタルが白華してしまい外観を著しくそこなってしまうことがありす。
白華はモルタル中の水酸化カルシウムが雨水や雪などの外的水分によって溶け出し、表面にでてくる事で空気中の二酸化炭素などと反応して炭酸カルシウムになってしまうことから起こってしまいます。
つまり、目地から雨水などが侵入しづらい処理を行っていれば白華をかなりの確率で防ぐことが可能となります。
モルタルに染み渡った水分が凍結すると、クラックの原因となります。また近年多発する地震や立地環境によっては地盤の揺れが多発しています。それらが起因することでもクラックがおこってしまいます。
漏れる前に充分強固な塗膜を形成しておくことで予防は十分可能です。
また、万が一クラックが原因で浸水がおきてしまった場合、浸水箇所を特定することが困難ですので、塗膜処理を行い面で防水層を掲載する事で浸水を防ぐ、つまり防水をおこなう事が出来ます。
外壁タイルへの防水工法は昨今の世情からも水系材料を使用することが推奨されてきているため、各社こぞって開発してきているようですが、中塗りの防水材のみが水系材料というものです。
そういった中で日本樹脂施工協同組合様よりお声がけ頂き、大日化成と共同開発で完全水系の透明度が高く外壁の動きにも充分追従できる防水材を開発をおこない、業界初となります、完全水系1材タイプによる、臭気の無い安心なJKクリアコートW工法を開発致しました。。
特殊ウレタン樹脂で形成される塗膜や超高強度特殊繊維を使用しているため、透明度は高く施工するタイルの意匠をそのまま活かすことが可能です。
上塗りの仕上げも艶あり・半艶と二種ありご希望の艶を選択して頂く事が可能です。
| 工程 | 使用材料 | トータル塗布量 (kg/u) |
乾燥硬化時間 (目安)※1 |
塗布方法 | |
| 1 | プライマー | JKクリアプライマーW | 0.1 | 2〜5時間 透明状態確認まで |
刷毛・ローラー (0.1kg/u以下x1〜2回) |
| 2 | 下塗り | JKクリアファイバーW | 0.6以上 | 3〜8時間 透明状態確認まで |
刷毛・ローラー (0.3kg/u以下) |
| 3 | 中塗材 | JKクリアファイバーW | 3〜8時間 透明状態確認まで |
刷毛・ローラー (0.3kg/u以下x1〜数回) ※2 |
|
| 4 | トップコート | JKクリアトップW(艶有・半艶) | 0.1 | 2〜5時間 透明状態確認まで |
刷毛・ローラー (2回塗り) |
※1 あくまでも目安時間になります。各工程、透明状態になってから更に1時間養生後に次工程を施工します。
※2 中塗りは、塗布回数を調整してトータル塗布量になるまで材料を塗布し、規定の膜厚になるように管理を行います。
〇 事前に下地処理(目地材補修・タイル洗浄等)を行ってからの施工となります。下地処理内容は、建物の状況により判断いたします。
○ 斜壁・面台等についてはご相談ください。
トップコートを塗布したろ紙を各5種類のカビと藻で4週間培養した結果
JKクリアコートW工法は日本樹脂施工協同組合様と大日化成株式会社が共同開発を
おこなったOEM供給製品となります。
JKクリアコートW工法についてのお問い合わせは、下記より日本樹脂施工協同組合様へ
お問合せ下さい。
日本樹脂施工協同組合は、昭和54年に設立した「日本樹脂施工協会」を基に、平成2年に新たに設立されたコンクリート 建造物の仕上げ材の落下防止や美観の向上をはかる等、補修・改修・補強工事を行う全国の専門業者が集まる団体です。
現在、全国に約150社おり、ほとんど調査・診断から設計・施工に関して長年の経験と優れた技術を持っております。 また、団体として重要文化財の保存工事や、国家資格の技能検定及び職業訓練の実施協力等を行っております。